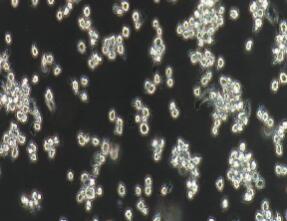
大鼠嗜碱性粒细胞性白血病细胞；NR8383

大鼠嗜碱性粒细胞性白血病细胞;NR8383
¥1900
1ml
起订
上海 更新日期:2026-04-17
产品详情:
- 中文名称:
- 大鼠嗜碱性粒细胞性白血病细胞;NR8383
- 保存条件:
- 常温或冻存
- 纯度规格:
- 99.99%
- 产品类别:
- 细胞生物学 细胞系
公司简介
上海康朗生物科技有限公司是一家集研发、生产、销售、服务于一体的一家生物科技企业,专营生化试剂、标准品、基因、蛋白、抗体、Elisa试剂盒、细胞生物学,分子生物学等高生物产品。总部位于上海,并在北京、广东,江西,吉林等全国30多个省市设有分公司和代理机构。涉及的产品被中国科学院、清华、北大、复旦,上海交大,复旦医学院,上海中医药大学,华东师范大学,第二军医大学,曙光医院,浦东新区人民医院等知名科研院所广泛使用,可靠而稳定的质量和完善的售后服务确。
| 成立日期 | (11年) |
| 注册资本 | 100万元整 |
| 员工人数 | 50-100人 |
| 年营业额 | ¥ 100万以内 |
| 经营模式 | 工厂 |
| 主营行业 | 中间体,化学试剂,医药原料 |
大鼠嗜碱性粒细胞性白血病细胞;NR8383相关厂家报价
-

- 大鼠嗜碱性粒细胞性白血病细胞RBL1
- 上海雅吉生物科技有限公司 VIP
- 2026-04-18
- ¥1500
-

- RBL2H3 Cells大鼠嗜碱性粒细胞性白血病细胞系(提供STR图谱)
- 上海冠导生物工程有限公司 VIP
- 2026-04-18
- 询价
-

- RBL-2H3细胞:大鼠嗜碱性粒细胞性白血病细胞系
- 上海宾穗生物科技有限公司 VIP
- 2026-04-18
- ¥1243